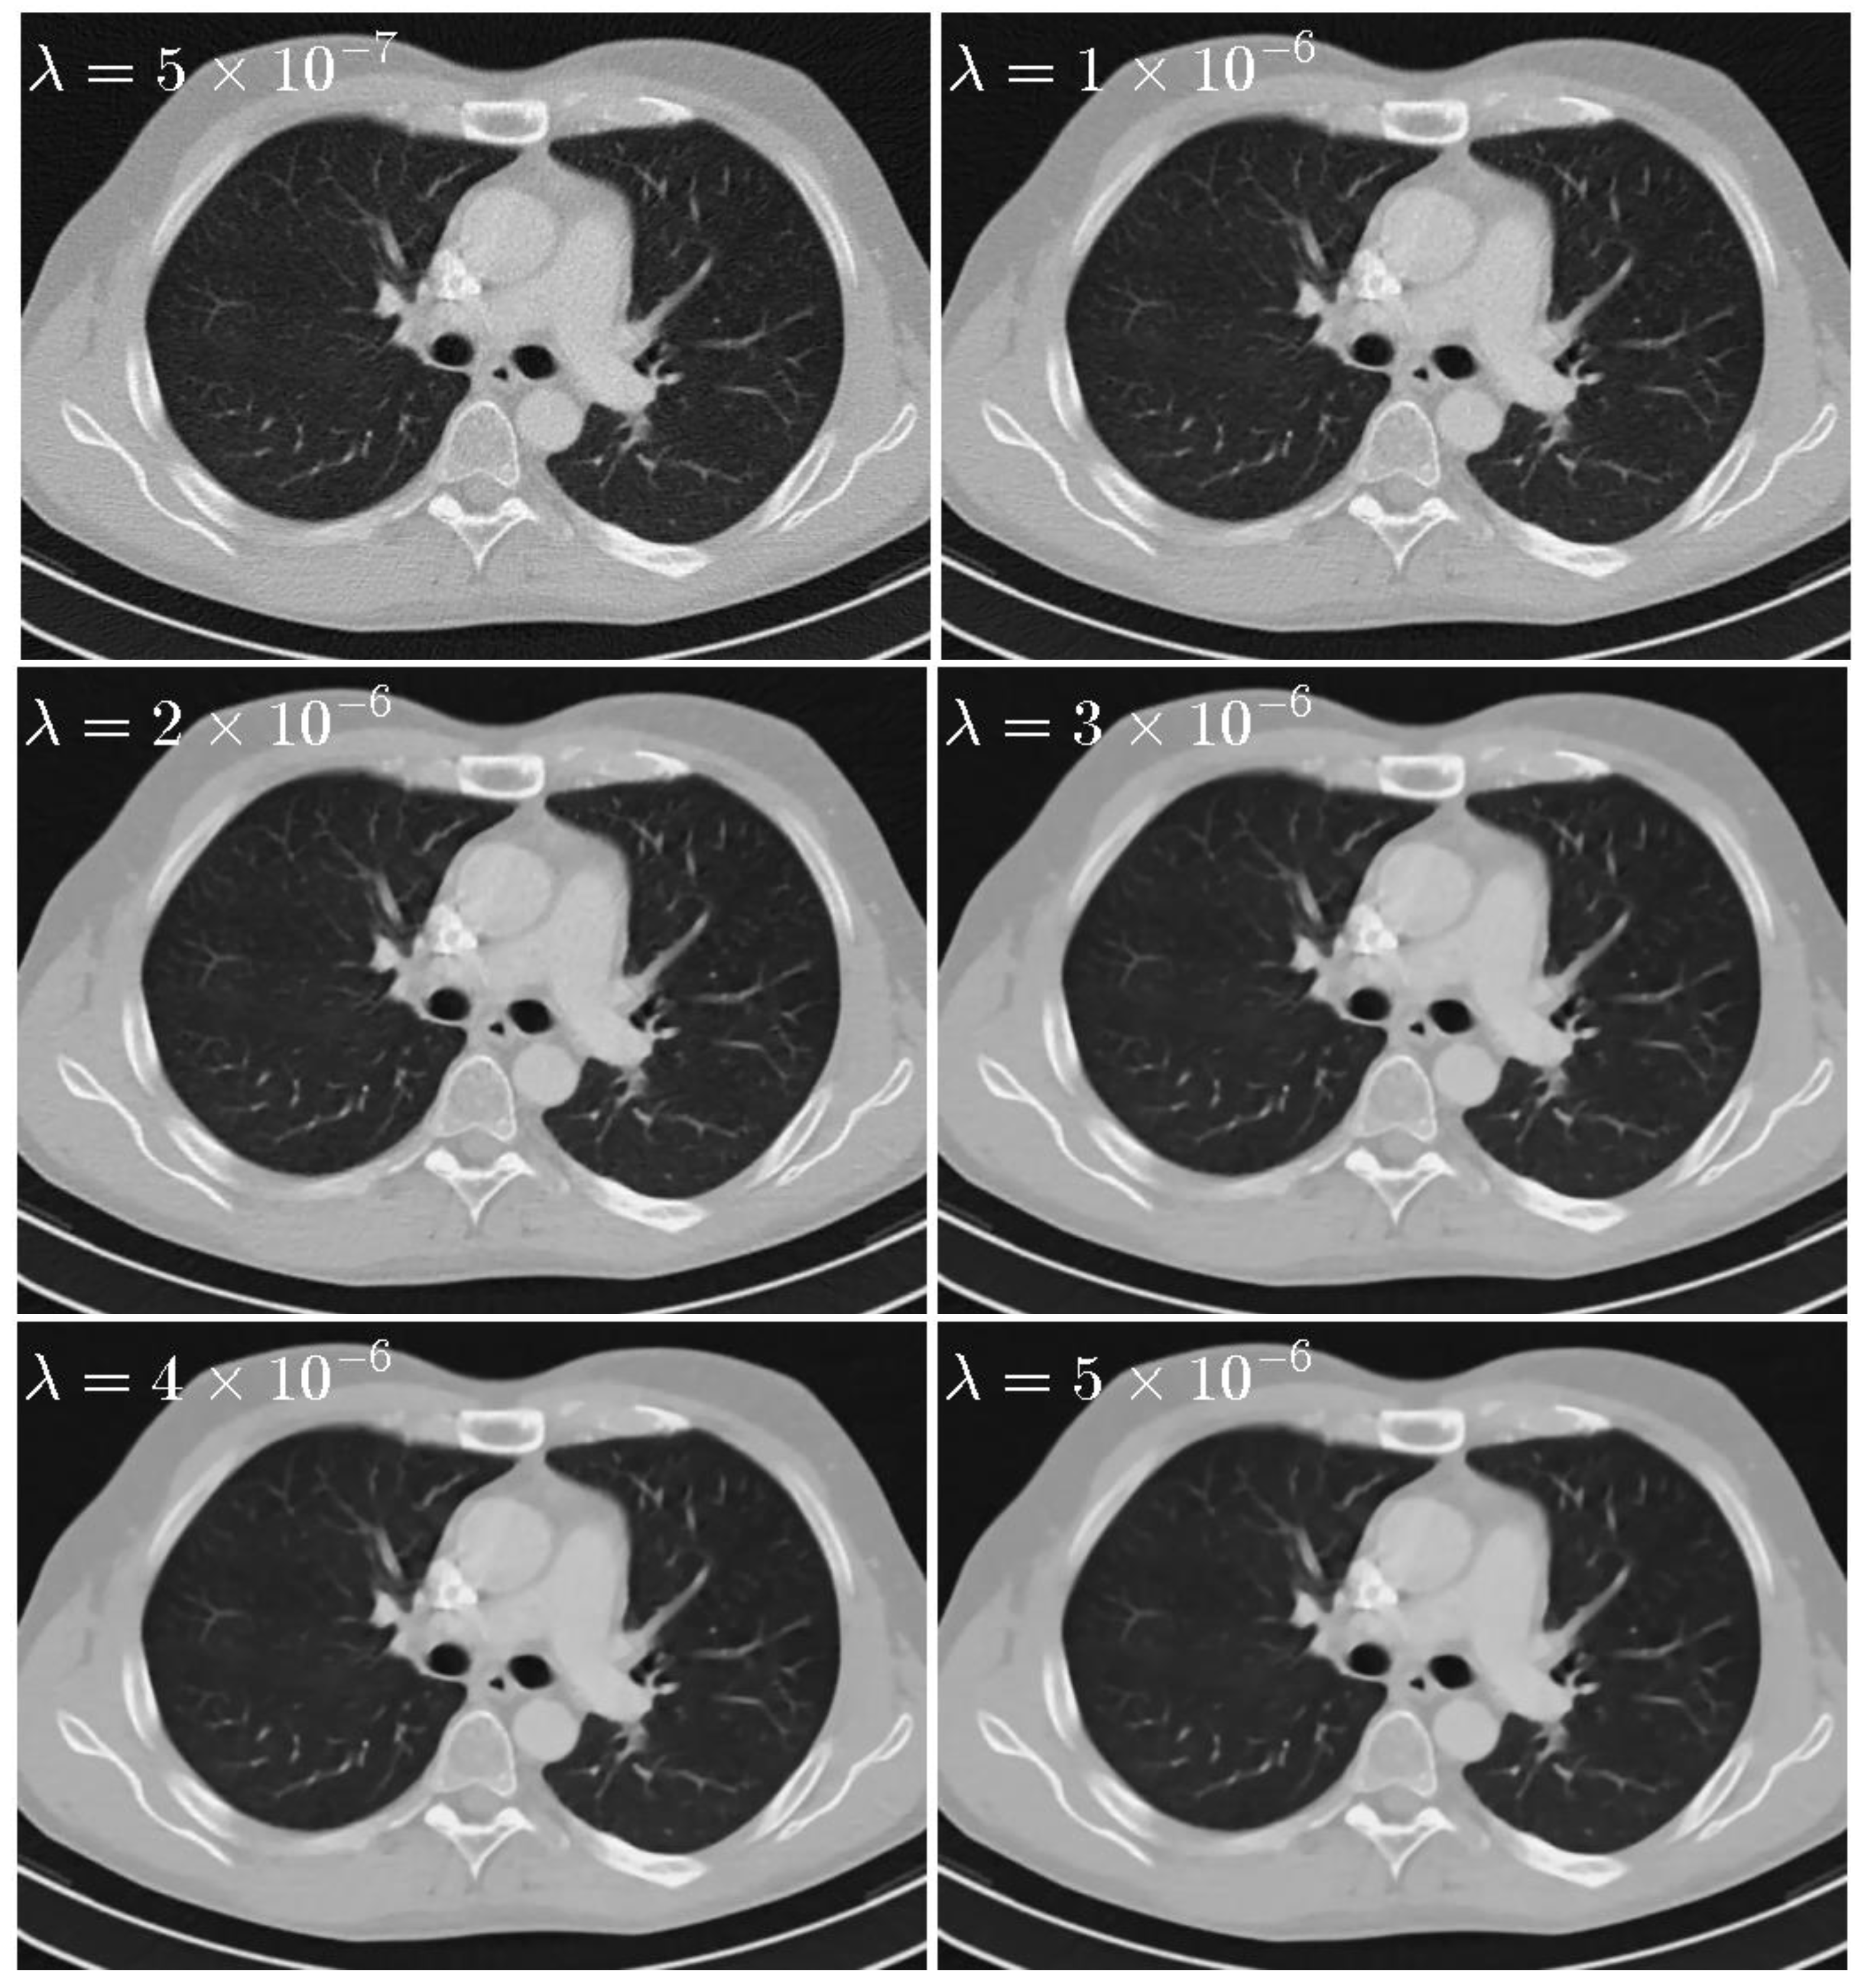
Sensors 20 01647 g006

Low Dose CT Image Reconstruction Based on Structure Tensor Total Variation Using Accelerated Fast Iterative Shrinkage Thresholding Algorithm
Abstract
1. Introduction
2. Materials and Methods
2.1. SIR
2.2. SIR with STV1 Penalty for Low Dose CT Reconstruction
2.3. AFISTA Algorithm for Solving SIR-STV1
2.3.1. General FISTA for Solving SIR-STV1
| Algorithm 1 Workflow of the general fast iterative shrinkage thresholding algorithm (FISTA). |
| Input: system matrix , projection data , Q is the Lipschitz constant of |
| Initial Step:, , maximum iteration number I, regularization parameter , convolution kernel |
| fori = 1,2,...,I |
| Update intermediate image with (7) |
| Update image with (8) |
| end for |
| output: |
2.3.2. AFISTA for Solving SIR-STV1
| Algorithm 2 Workflow of the progressive proximal map algorithm |
| Input:, , |
| Initial Step:, |
| fori = 1,2,...,I |
| end for |
| Output |
| Algorithm 3 Workflow of the proposed accelerated (A)FISTA |
| Input: System matrix , projection data , , , |
| Initial Step:, , maximum iteration number I, regularization parameter , convolution kernel K, the number of order subset M |
| fori = 1,2...I |
| for m = 1,...M |
| Update intermediate image using Equation (10): |
| , , are submatrices of , , corresponding to the mth subset |
| Update image with progressive proximal map algorithm using Algorithm 2 |
| end for |
| end for |
| Output |
3. Experimental Results
3.1. Brain Image Numerical Simulation
3.1.1. Convergence Analysis
3.1.2. Visual Quality Comparison
3.1.3. Quantitative Comparison
3.2. Thorax Image Numerical Simulation
3.2.1. Visual Quality Comparison
3.2.2. Quantitative Comparison
3.2.3. Profile-Based Comparison
3.2.4. Analysis of the Parameter
3.3. Realistic Sheep Lung Experiments
4. Discussion and Conclusions
Author Contributions
Funding
Acknowledgments
Conflicts of Interest
References
- Brenner, D.J.; Elliston, C.D.; Hall, E.J.; Berdon, W.E. Estimated risks of radiation-induced fatal cancer from pediatric ct. Am. J. Roentgenol. 2001, 176, 289–296. [Google Scholar] [CrossRef]
- Hall, E.J.; Brenner, D.J. Cancer risks from diagnostic radiology. Br. J. Radiol. 2008, 81, 362–378. [Google Scholar] [CrossRef]
- de Gonzalez, A.B.; Mahesh, M.; Kim, K.P.; Bhargavan, M.; Lewis, R.; Mettler, F.; Land, C. Projected cancer risks from computed tomographic scans performed in the united states in 2007. Arch. Intern. Med. 2009, 169, 2071–2077. [Google Scholar] [CrossRef] [PubMed]
- Naidich, D.P.; Marshall, C.H.; Gribbin, C.; Arams, R.S.; Mccauley, D.I. Low-dose ct of the lungs: Preliminary observations. Radiology 1990, 175, 729–731. [Google Scholar] [CrossRef] [PubMed]
- Elbakri, I.A.; Fessler, J.A. Statistical image reconstruction for polyenergetic x-ray computed tomography. IEEE Trans. Med. Imaging 2002, 21, 89–99. [Google Scholar] [CrossRef] [PubMed]
- Donghwan, K.; Sathish, R.; Fessler, J.A. Combining ordered subsets and momentum for accelerated X-ray ct image reconstruction. IEEE Trans. Med. Imaging 2015, 34, 167–178. [Google Scholar]
- Donoho, D.L. Compressed sensing. IEEE Trans. Inf. Theory 2006, 52, 1289–1306. [Google Scholar] [CrossRef]
- Sidky, E.Y.; Xiaochuan, P. Image reconstruction in circular cone-beam computed tomography by constrained, total-variation minimization. Phys. Med. Biol. 2008, 53, 4777. [Google Scholar] [CrossRef]
- Tang, J.; Nett, B.E.; Chen, G.H. Performance comparison between total variation (tv)-based compressed sensing and statistical iterative reconstruction algorithms. Phys. Med. Biol. 2009, 54, 5781–5804. [Google Scholar] [CrossRef]
- Choi, K.; Wang, J.; Zhu, L.; Suh, T.S.; Boyd, S.; Xing, L. Compressed sensing based cone-beam computed tomography reconstruction with a first-order method. Med. Phys. 2010, 37, 5113–5125. [Google Scholar]
- Xu, Q.; Yu, H.; Mou, X.; Zhang, L.; Hsieh, J.; Wang, G. Low-dose X-ray ct reconstruction via dictionary learning. IEEE Trans. Med. Imaging 2012, 31, 1682–1697. [Google Scholar] [PubMed]
- Sun, T.; Sun, N.; Wang, J.; Tan, S. Iterative cbct reconstruction using hessian penalty. Phys. Med. Biol. 2015, 60, 1965–1987. [Google Scholar] [CrossRef] [PubMed]
- Zhang, J.; Chen, Y.; Hu, Y.; Luo, L.; Shu, H.; Li, B.; Liu, J.; Coatrieux, J.L. Gamma regularization based reconstruction for low dose ct. Phys. Med. Biol. 2015, 60, 6901–6921. [Google Scholar] [CrossRef] [PubMed][Green Version]
- Shangguan, H.; Zhang, Q.; Liu, Y.; Cui, X.; Bai, Y.; Gui, Z. Low-dose ct statistical iterative reconstruction via modified mrf regularization. Comput. Methods Programs Biomed. 2016, 123, 129–141. [Google Scholar] [CrossRef] [PubMed]
- Shi, Q.; Sun, N.; Sun, T.; Wang, J.; Tan, S. Structure-adaptive cbct reconstruction using weighted total variation and hessian penalties. Biomed. Opt. Express 2016, 7, 3299–3322. [Google Scholar] [CrossRef] [PubMed]
- Xu, Q.; Yang, D.; Tan, J.; Sawatzky, A.; Anastasio, M.A. Accelerated fast iterative shrinkage thresholding algorithms for sparsity-regularized cone-beam ct image reconstruction. Med. Phys. 2016, 43, 1849. [Google Scholar] [CrossRef] [PubMed]
- Zhang, Y.; Wang, Y.; Zhang, W.; Lin, F.; Pu, Y.; Zhou, J. Statistical iterative reconstruction using adaptive fractional order regularization. Opt. Express 2016, 7, 1015. [Google Scholar] [CrossRef]
- Liu, L.; Li, X.; Xiang, K.; Wang, J.; Tan, S. Low-dose cbct reconstruction using hessian schatten penalties. IEEE Trans. Med. Imaging 2017, 36, 2588–2599. [Google Scholar] [CrossRef]
- Kim, K.; El, F.G.; Li, Q. Low-dose ct reconstruction using spatially encoded nonlocal penalty. Med. Phys. 2017, 44, 376. [Google Scholar] [CrossRef]
- Cai, A.; Li, L.; Zheng, Z.; Wang, L.; Yan, B. Block-matching sparsity regularization-based image reconstruction for low-dose computed tomography. Med. Phys. 2018, 45, 2439–2452. [Google Scholar] [CrossRef]
- Lefkimmiatis, S.; Roussos, A.; Maragos, P.; Unser, M. Structure tensor total variation. SIAM J. Imaging Sci. 2015, 8, 1090–1122. [Google Scholar] [CrossRef]
- Zeng, D.; Gao, Y.; Huang, J.; Bian, Z.; Zhang, H.; Lu, L.; Ma, J. Penalized weighted least-squares approach for multienergy computed tomography image reconstruction via structure tensor total variation regularization. Comput. Med. Imaging Graph. 2016, 53, 19–29. [Google Scholar] [CrossRef] [PubMed]
- Zeng, D.; Zhang, X.; Bian, Z.; Huang, J.; Zhang, H.; Lu, L.; Lyu, W.; Zhang, J.; Feng, Q.; Chen, W. Cerebral perfusion computed tomography deconvolution via structure tensor total variation regularization. Med. Phys. 2016, 43, 2091–2107. [Google Scholar] [CrossRef] [PubMed]
- Gong, C.; Han, C.; Gan, G.; Deng, Z.; Zhou, Y.; Yi, J.; Zheng, X.; Xie, C.; Jin, X. Low-dose dynamic myocardial perfusion ct image reconstruction using pre-contrast normal-dose ct scan induced structure tensor total variation regularization. Phys. Med. Biol. 2017, 62, 2612. [Google Scholar] [CrossRef] [PubMed]
- Beck, A.; Teboulle, M. A fast iterative shrinkage-thresholding algorithm for linear inverse problems. SIAM J. Imaging Sci. 2009, 2, 183–202. [Google Scholar] [CrossRef]
- Sathish, R.; Fessler, J.A. A splitting-based iterative algorithm for accelerated statistical X-ray ct reconstruction. IEEE Trans. Med. Imaging 2012, 31, 677–688. [Google Scholar]
- Dutta, J.; Ahn, S.; Li, C.; Cherry, S.R.; Leahy, R.M. Joint l1 and total variation regularization for fluorescence molecular tomography. Phys. Med. Biol. 2012, 57, 1459. [Google Scholar] [CrossRef]
- Wang, A.S.; Stayman, J.W.; Otake, Y.; Vogt, S.; Kleinszig, G.; Siewerdsen, J.H. Accelerated statistical reconstruction for c-arm cone-beam ct using nesterov’s method. Phys. Med. Biol. 2015, 42, 2699. [Google Scholar] [CrossRef]
- Erdogan, H.; Fessler, J.A. Ordered subsets algorithms for transmission tomography. Phys. Med. Biol. 1999, 44, 2835–2851. [Google Scholar] [CrossRef]
- Simulation with DICOM CT Images. Available online: https://wiki.kek.jp/pages/viewpage.action?pageId=13667347 (accessed on 15 January 2017).
- Liu, J.; Ma, J.; Zhang, Y.; Chen, Y.; Yang, J.; Shu, H.; Luo, L.; Coatrieux, G.; Yang, W.; Feng, Q. Discriminative feature representation to improve projection data inconsistency for low dose ct imaging. IEEE Trans. Med. Imaging 2018, 36, 2499–2509. [Google Scholar] [CrossRef]
- Zhou, W.; Alan Conrad, B.; Hamid Rahim, S.; Eero, P.S. Image quality assessment: From error visibility to structural similarity. IEEE Trans. Image Process. 2004, 13, 600–612. [Google Scholar]
- Herz-CT. Available online: https://www.radiolog.at/start.php?bereich=ct_mr&nav=untersuchun (accessed on 20 January 2017).

| Incident Photon Number | Algorithm | PSNR (dB) | RRE | SSIM |
|---|---|---|---|---|
| 5 × 103 | FBP | 26.6131 | 0.2049 | 0.5526 |
| SIR-TV | 33.8416 | 0.0892 | 0.7539 | |
| SIR-STV1 | 35.7597 | 0.0715 | 0.7639 | |
| 1 × 104 | FBP | 29.8176 | 0.1417 | 0.6135 |
| SIR-TV | 35.7454 | 0.0716 | 0.8162 | |
| SIR-STV1 | 38.2683 | 0.0536 | 0.8248 | |
| 5 × 104 | FBP | 36.7103 | 0.0641 | 0.7318 |
| SIR-TV | 40.2409 | 0.0427 | 0.9016 | |
| SIR-STV1 | 42.8079 | 0.0307 | 0.9275 |
| Different ROI | Algorithm | PSNR (dB) | RRE | SSIM |
|---|---|---|---|---|
| ROI 1 | FBP | 30.7537 | 0. 0447 | 0.7403 |
| SIR-TV | 35.0948 | 0.0271 | 0.9206 | |
| SIR-STV1 | 35.7648 | 0.0251 | 0.9370 | |
| ROI 2 | FBP | 29.9316 | 0.0540 | 0.7730 |
| SIR-TV | 33.1043 | 0.0374 | 0.9145 | |
| SIR-STV1 | 34.2960 | 0.0326 | 0.9348 | |
| ROI 3 | FBP | 30.0721 | 0.0446 | 0.7021 |
| SIR-TV | 33.8564 | 0.0288 | 0.8927 | |
| SIR-STV1 | 34.9798 | 0.0253 | 0.9183 |
| Parameter | PSNR (dB) | RRE | SSIM |
|---|---|---|---|
| , LK = 3 | 37.7983 | 0.0290 | 0.9449 |
| , LK = 5 | 37.9762 | 0.0283 | 0.9477 |
| , LK = 7 | 37.9653 | 0.0284 | 0.9482 |
| , LK = 9 | 37.8765 | 0.0287 | 0.9480 |
| , LK = 11 | 37.7748 | 0.0291 | 0.9474 |
| , LK = 13 | 37.6704 | 0.0294 | 0.9466 |
© 2020 by the authors. Licensee MDPI, Basel, Switzerland. This article is an open access article distributed under the terms and conditions of the Creative Commons Attribution (CC BY) license (http://creativecommons.org/licenses/by/4.0/).
Share and Cite
Wu, J.; Wang, X.; Mou, X.; Chen, Y.; Liu, S. Low Dose CT Image Reconstruction Based on Structure Tensor Total Variation Using Accelerated Fast Iterative Shrinkage Thresholding Algorithm. Sensors 2020, 20, 1647. https://doi.org/10.3390/s20061647
Wu J, Wang X, Mou X, Chen Y, Liu S. Low Dose CT Image Reconstruction Based on Structure Tensor Total Variation Using Accelerated Fast Iterative Shrinkage Thresholding Algorithm. Sensors. 2020; 20(6):1647. https://doi.org/10.3390/s20061647
Chicago/Turabian StyleWu, Junfeng, Xiaofeng Wang, Xuanqin Mou, Yang Chen, and Shuguang Liu. 2020. "Low Dose CT Image Reconstruction Based on Structure Tensor Total Variation Using Accelerated Fast Iterative Shrinkage Thresholding Algorithm" Sensors 20, no. 6: 1647. https://doi.org/10.3390/s20061647
APA StyleWu, J., Wang, X., Mou, X., Chen, Y., & Liu, S. (2020). Low Dose CT Image Reconstruction Based on Structure Tensor Total Variation Using Accelerated Fast Iterative Shrinkage Thresholding Algorithm. Sensors, 20(6), 1647. https://doi.org/10.3390/s20061647





